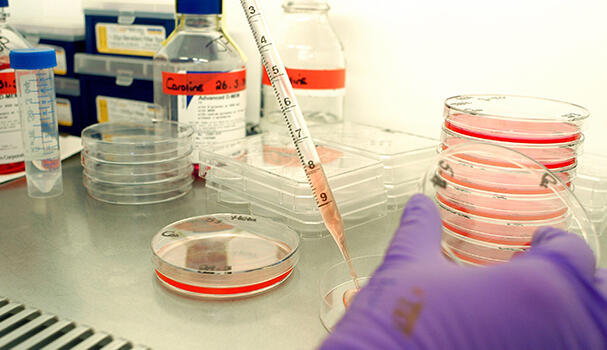
Scientist with culture plate sample

Kidney cancer patient stories

120 years of life-saving discoveries
Our scientists have been at the forefront of cancer research since 1902.
Thanks to you, we’ve come so far. And we will go much further.
Together, we will beat cancer.
Stories from kidney cancer patients
Helping more people survive cancer is the aim of everything we do. Read stories from people who have been affected by kidney cancer, and how research has made a difference to them.